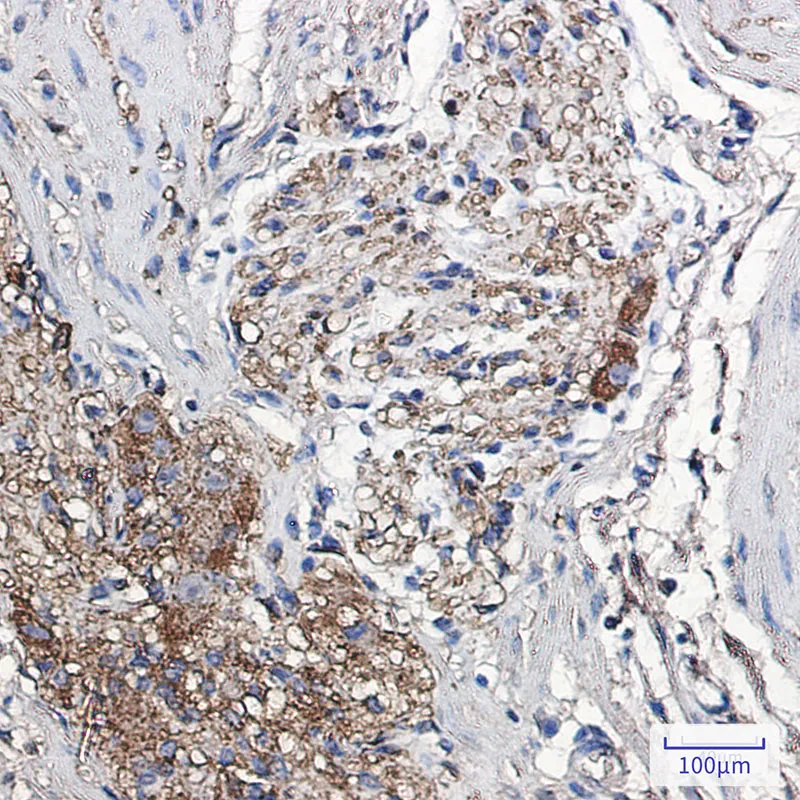
alpha Synuclein Rabbit Monoclonal Antibody

Size:100μL Price:$288
Size:200μL Price:$520
Application:WB,IHC,IP
Reactivity:Human,Rat
Conjugate:Unconjugated
Optional conjugates: Biotin, FITC (free of charge). See other 26 conjugates.
Gene Name:SNCA
Summary
| Production Name | alpha Synuclein Rabbit Monoclonal Antibody |
| Description | Recombinant rabbit monoclonal antibody |
| Host | Rabbit |
| Application | WB,IHC,IP |
| Reactivity | Human,Rat |
Performance
| Conjugation | Unconjugated |
| Modification | Unmodified |
| Isotype | IgG |
| Clonality | Monoclonal |
| Form | Liquid |
| Storage | Store at 4°C short term. Aliquot and store at -20°C long term. Avoid freeze/thaw cycles. |
| Buffer | 50mM Tris-Glycine(pH 7.4), 0.15M NaCl, 40% Glycerol, 0.01% Sodium azide and 0.05% protective protein |
| Purification | Affinity Purification |
Immunogen
| Gene Name | SNCA |
| Alternative Names | SNCA; NACP; PARK1; Alpha-synuclein; Non-A beta component of AD amyloid; Non-A4 component of amyloid precursor; NACP |
| Gene ID | 6622 |
| SwissProt ID | P37840 |
Application
| Dilution Ratio | WB 1:500-1:1000,IHC 1:50-1:100,IP 1:20-1:50 |
| Molecular Weight | Calculated MW: 14 kDa; Observed MW: 18 kDa |
Background
May be involved in the regulation of dopamine release and transport. Induces fibrillization of microtubule-associated protein tau. Reduces neuronal responsiveness to various apoptotic stimuli, leading to a decreased caspase-3 activation. Genetic alterations of SNCA resulting in aberrant polymerization into fibrils, are associated with several neurodegenerative diseases (synucleinopathies).
Research Area
Neuroscience
